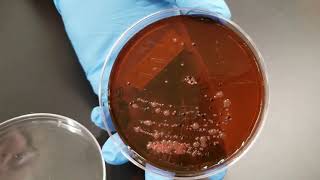
Microbiology of Water: Confirmed Test

Download Lagu MP3 & Video: Bacteriological Examination Of Drinking Water English
Coliform Bacteria Test Kit - How to Test For Coliform Bacteria in Water (2019)
Health Metric - 6 years ago
Download
Microbiological Testing of Drinking water (MLT) by Dr.Kapil Swami
Kapil Swami - 5 years ago
Download
Bacteriological Analysis Water By Most Probable Number (MPN) Technique 🧪
Jahanvi Joshi - 2 years ago
Download